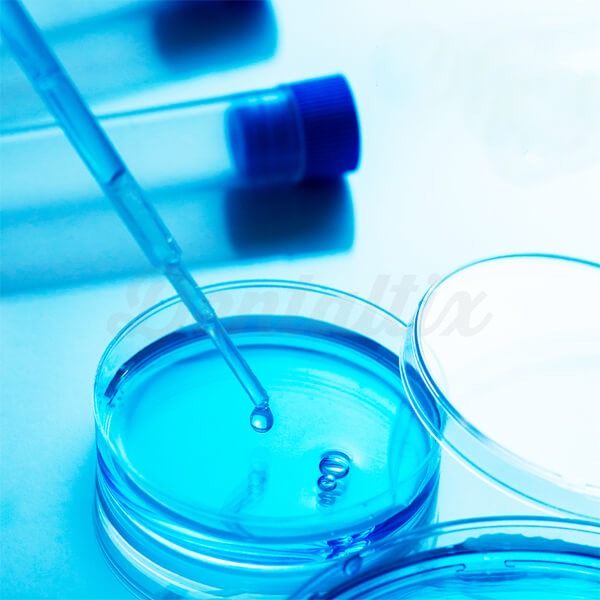

Referencia:
DTX-BU0158
-30%
6352€
Precio IVA incluido (21%) 76,86 €Precio recomendado: 90,74 €
Kit de Análisis de Legionella en Agua para Equipos Dentales - BADER
Marca: BADER
Referencia: DTX-BU0158
Ref. Fabricante: U0158
-30%
6352€
Precio IVA incluido (21%) 76,86 €Precio recomendado: 90,74 €
Análisis de legionela:
- Servicio exclusivo para garantizar la calidad del agua de los equipos dentales.
- Kit de un laboratorio certificado.
- Incluye una nevera portátil y una botella de agua especializada para recogida de muestras (1 litro).
Producto similar recomendado:
6352€
EN STOCK.
Entrega más rápida entre jueves, 23 de octubre - viernes, 24 de octubre haciendo tu pedido antes de .

Análisis de legionela:
- Servicio exclusivo para garantizar la calidad del agua de los equipos dentales.
- Kit de un laboratorio certificado.
- Incluye una nevera portátil y una botella de agua especializada para recogida de muestras (1 litro).
Producto similar recomendado:
Descripción
Análisis de Legionella en Agua para Equipos Dentales
Características del Análisis de Legionella en Agua para Equipos Dentales:
- Servicio exclusivo para garantizar la calidad del agua de los equipos dentales.
- Kit de un laboratorio certificado.
- Incluye una nevera portátil y una botella de agua especializada para recogida de muestras (1 litro).
- Hay que llenar la botella con pequeñas muestras de agua de todos los lugares que salga agua del equipo.
- Si el laboratorio verifica que no hay legionella en tus equipos, recibirás un certificado completo que certifica la pureza y calidad del agua de su equipo.
- Cada kit sirve para un equipo dental a analizar.
- No admite devolución.
- El cliente debe enviar la muestra a un laboratorio cercano. Desde que se toma la muestra hasta que llega al laboratorio no debe pasar mas de 24hrs.
Preguntas y respuestas
Aún no hay ninguna pregunta, sé el primero.
Es necesarion estár autentificado para poder realizar preguntas. Iniciar sesión